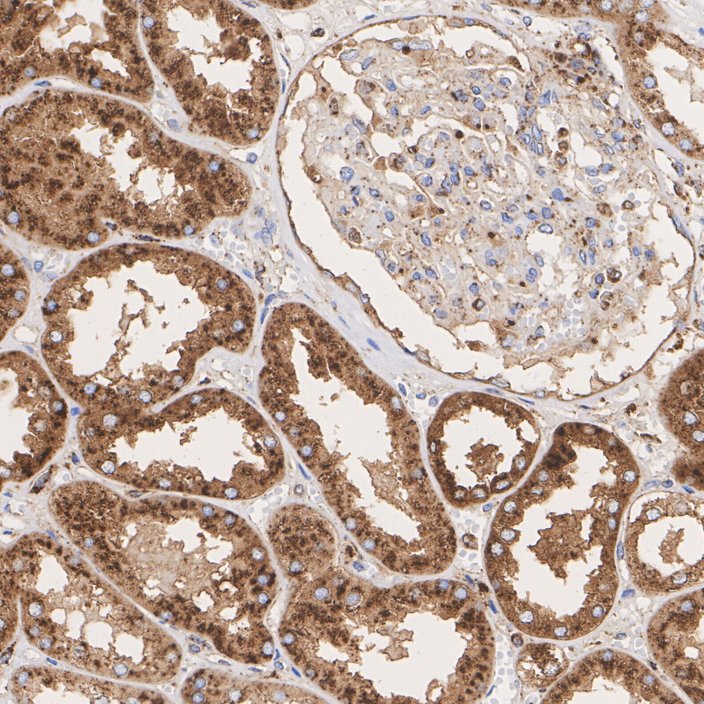
HA751183_3.jpg

ASAH1 Recombinant Rabbit Monoclonal Antibody [PSH07-71]

cat.: HA751183
| Product Type: | Recombinant Rabbit monoclonal IgG, primary antibodies |
|---|---|
| Species reactivity: | Human |
| Applications: | WB, IHC-P |
| Clonality: | Monoclonal |
| Clone number: | PSH07-71 |
| Form: | Liquid |
| Storage condition: | Store at +4℃ after thawing. Aliquot store at -20℃. Avoid repeated freeze / thaw cycles. |
| Storage buffer: | 1*PBS (pH7.4). |
| Concentration: | 1ug/ul |
| Purification: | Protein A affinity purified. |
| Molecular weight: | Predicted band size: 45 kDa |
| Isotype: | IgG |
| Immunogen: | Recombinant protein within human ASAH1 aa 1-395. |
| Positive control: | SK-MEL-28 cell lysate, MDA-MB-231 cell lysate, SH-SY5Y cell lysate, human brain tissue, human kidney tissue. |
| Subcellular location: | Lysosome, Secreted; Nucleus, Cytoplasm. |
| Recommended Dilutions:
WB IHC-P |
1:2,000 1:1,000 |
| Uniprot #: | SwissProt: Q13510 Human |
| Alternative names: | AC ACDase Acid CDase Acid ceramidase Acid ceramidase precursor Acid ceramidase subunit beta Acylsphingosine deacylase ASAH 1 ASAH ASAH1 ASAH1_HUMAN FLJ21558 FLJ22079 N acylsphingosine amidohydrolase (acid ceramidase) 1 N acylsphingosine amidohydrolase 1 N acylsphingosine amidohydrolase N-acylsphingosine amidohydrolase N-acylsphingosine deacylase PHP PHP32 Putative 32 kDa heart protein SMAPME |
Images

|
Fig1:
Western blot analysis of ASAH1 on different lysates with Rabbit anti-ASAH1 antibody (HA751183) at 1/2,000 dilution. Lane 1: SK-MEL-28 cell lysate Lane 2: MDA-MB-231 cell lysate Lane 3: SH-SY5Y cell lysate Lysates/proteins at 20 µg/Lane. Predicted band size: 45 kDa Observed band size: 37/55 kDa Exposure time: 20 seconds; ECL: K1801; 4-20% SDS-PAGE gel. Proteins were transferred to a PVDF membrane and blocked with 5% NFDM/TBST for 1 hour at room temperature. The primary antibody (HA751183) at 1/2,000 dilution was used in 5% NFDM/TBST at 4℃ overnight. Goat Anti-Rabbit IgG - HRP Secondary Antibody (HA1001) at 1/50,000 dilution was used for 1 hour at room temperature. |

|
Fig2:
Immunohistochemical analysis of paraffin-embedded human brain tissue with Rabbit anti-ASAH1 antibody (HA751183) at 1/1,000 dilution. The section was pre-treated using heat mediated antigen retrieval with Tris-EDTA buffer (pH 9.0) for 20 minutes. The tissues were blocked in 1% BSA for 20 minutes at room temperature, washed with ddH2O and PBS, and then probed with the primary antibody (HA751183) at 1/1,000 dilution for 1 hour at room temperature. The detection was performed using an HRP conjugated compact polymer system. DAB was used as the chromogen. Tissues were counterstained with hematoxylin and mounted with DPX. |
|
Fig3:
Immunohistochemical analysis of paraffin-embedded human kidney tissue with Rabbit anti-ASAH1 antibody (HA751183) at 1/1,000 dilution. The section was pre-treated using heat mediated antigen retrieval with Tris-EDTA buffer (pH 9.0) for 20 minutes. The tissues were blocked in 1% BSA for 20 minutes at room temperature, washed with ddH2O and PBS, and then probed with the primary antibody (HA751183) at 1/1,000 dilution for 1 hour at room temperature. The detection was performed using an HRP conjugated compact polymer system. DAB was used as the chromogen. Tissues were counterstained with hematoxylin and mounted with DPX. |
Note: All products are “FOR RESEARCH USE ONLY AND ARE NOT INTENDED FOR DIAGNOSTIC OR THERAPEUTIC USE”.